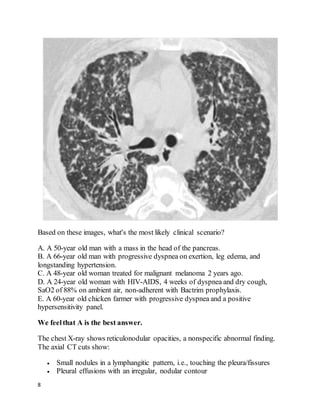
8
Based on these images, what's the most likely clinical scenario?
A. A 50-year old man with a mass in the head of the pancreas.
B. A 66-year old man with progressive dyspnea on exertion, leg edema, and
longstanding hypertension.
C. A 48-year old woman treated for malignant melanoma 2 years ago.
D. A 24-year old woman with HIV-AIDS, 4 weeks of dyspnea and dry cough,
SaO2 of 88% on ambient air, non-adherent with Bactrim prophylaxis.
E. A 60-year old chicken farmer with progressive dyspnea and a positive
hypersensitivity panel.
We feelthat A is the best answer.
The chest X-ray shows reticulonodular opacities, a nonspecific abnormal finding.
The axial CT cuts show:
 Small nodules in a lymphangitic pattern, i.e., touching the pleura/fissures
 Pleural effusions with an irregular, nodular contour

This patient presented with left leg swelling and edema. Ultrasound of the left common femoral vein showed a non-compressible vein with echogenic material in the lumen, consistent with deep vein thrombosis (DVT). As this was an unprovoked, proximal DVT, the best recommendation is to start enoxaparin and warfarin, then discharge the patient with instructions to continue warfarin indefinitely, in accordance with ACCP guidelines for long-term anticoagulation in patients with unprovoked proximal DVT.

![54
clinical trials in the 1980s and is not available in the United States,[2] although it
can be purchased on the Internet.
EmergencyDepartment Care
Initial emergency department care for patients with cyanide exposure is identical to
that provided in the prehospital phase.
Provide supportive care, including the following:
Airway control, ventilation, 100% oxygen delivery
Crystalloids and vasopressors, as needed, for hypotension
Sodium bicarbonate titrated according to arterial blood gas (ABG) and
serum bicarbonate level
Decontaminate the patient with removal of clothing/skin flushing and/or activated
charcoal (1g/kg), as appropriate. Activated charcoal should be given after oral
exposure in alert patients who are able to protect the airway or after endotracheal
intubation in unconscious patients. Remember to protectthe health-care provider
from potential contamination.
Administer cyanide antidotes if the diagnosis is strongly suspected, without
waiting for laboratory confirmation. The antidotes include hydroxocobalamin
(Cyanokit) and the Cyanide Antidote Kit, which includes amyl nitrite pearls,
sodium nitrite, and sodium thiosulfate.
Cyanokit
Hydroxocobalamin (Cyanokit), routinely used in Europe, has been approved by the
US Food and Drug Administration (FDA) for treating known or suspected cyanide
poisoning.[7, 8]
Hydroxocobalamin combines with cyanide to form cyanocobalamin (vitamin B-
12), which is renally cleared. Hydroxocobalamin administration resulted in faster](https://image.slidesharecdn.com/cases-150409121051-conversion-gate01/85/Real-World-Boards-Cases-PULMCCM-54-320.jpg)
![55
improvement in mean arterial pressure but similar mortality and serum acidosis, as
compared with sodium nitrite, in animals.[9]
A repeat doseof hydroxocobalamin and/or coadministration of sodium thiosulfate
(through a separate line or sequentially) have been suggested to improve
detoxification and are recommended in patients with continuing elevated lactate
levels or continuing signs of cyanide toxicity.[10, 11]
Adverse effects of hydroxocobalamin administration include transient hypertension
(a benefit in hypotensive patients), reddish brown skin, mucous membrane and
urine discoloration, and rare anaphylaxis and anaphylactoid reactions. It also
interferes with co-oximetry (about a 5% increase in carboxyhemoglobin levels)
and blood chemistry testing (bilirubin, creatinine kinase and possibly liver
enzymes, creatinine, phosphorus,glucose, magnesium, and iron levels) due to its
bright red color.[12] It can also interfere with hemodialysis.[13]
Certain medications should not be administered simultaneously or through the
same line as hydroxocobalamin, including diazepam, dopamine, dobutamine, and
sodium thiosulfate.
Cyanide Antidote Kit
The Cyanide Antidote Kit contains amyl nitrite pearls, sodium nitrite, and sodium
thiosulfate. Amyl and sodium nitrites induce 15-20% methemoglobinemia in red
blood cells, with methemoglobin combining with cyanide and releasing
cytochrome oxidase enzyme. Inhaling crushed amyl nitrite pearls is a temporizing
measure before IV administration of sodium nitrite.
Sodium thiosulfate enhances the conversion of cyanide to thiocyanate, which is
renally excreted. Thiosulfate has a somewhat delayed effect and thus is typically
used with sodium nitrite for faster antidote action.
Avoid the nitrite portion of the kit in patients with smoke inhalation unless
carboxyhemoglobin concentration is very low (< 10%). The induction of
methemoglobinemia from the nitrites, in addition to present
carboxyhemoglobinemia, significantly reduces the oxygen-carrying capacity of
blood.
In patients with preexisting anemia, the sodium nitrite doseneeds to be reduced
dosein proportion to the hemoglobin concentration. Consult a regional toxicology
center for appropriate dosing.](https://image.slidesharecdn.com/cases-150409121051-conversion-gate01/85/Real-World-Boards-Cases-PULMCCM-55-320.jpg)










![66
Question 33 of 82 (score?)
You are using airway pressure release ventilation (APRV or "bi-level") for Ms. P,
a 76-year-old woman with ARDS from sepsis. She has been on mechanical
ventilation for 5 days. She is in shockand is on vasopressors. Her ventilator
settings are:
P[high] = 30; P[low] = 0
T[high] = 5 sec; T[low] = 0.6 sec
PEEP = 0; FiO2 = 0.55
Her most recent arterial blood gases are:
pH 7.25, paCO252; paO2 62 (8 hours ago)
pH 7.19, paCO262; paO2 60 (30 minutes ago)
Her ideal bodyweight is 60 kg and she is receiving tidal volumes (Vt) of 360 mL.
Mean airway pressure is 24 mmHg.
The bestthing to do next would be to:
A. Increase FiO2 to 0.65
B. Increase PEEP to 5
C. Decrease T[high] to 4 sec
D. Decrease P[high] to achieve Vt of 5mL / kg
E. Decrease T[low] to 0.4 sec
We feelthat C is the best answer.
Ms P is hypoventilating due to an inadequate minute ventilation being delivered.
Airway pressure release ventilation (APRV or "bi-level") cycles between two
alternating levels of CPAP, P[high] and P[low], whose durations are determined by
T[high] (usually several seconds)and T[low] (usually a fraction of a second). This
pattern maintains a stable high mean airway pressure, keeping alveoli open and](https://image.slidesharecdn.com/cases-150409121051-conversion-gate01/85/Real-World-Boards-Cases-PULMCCM-66-320.jpg)
![67
augmenting oxygenation--an "openlung" strategy. APRV can also be viewed as a
form of pressure-controlled, inverse-ratio ventilation. Ventilation (exhaled tidal
volume and CO2) occurs during the pressure drop from P[high] to P[low] (hence
"pressure release ventilation"). PEEP is usually set to 0, but the short time at
P[low] creates beneficial auto-PEEP and prevents alveolar collapse. Patients may
take small additional breaths throughout the entire cycle; these Vt improve alveolar
recruitment and oxygenation but contribute little to minute ventilation.
The most effective way to increase minute ventilation in APRV is to decrease
T[high], which increases the frequency of breaths. Although Ms P's ABG is
acceptable for a patient with ARDS, her acidemia is worsening. Many would argue
that hypercarbic respiratory acidemia (down to pH of 7.15 or so)is well-tolerated
and poses little risk. However, the trend is concerning and potentially dangerous
should it continue. This is an easy ventilator change to make with no apparent risk.
Reducing minute ventilation further by reducing delivered tidal volumes would be
unwise when peak and mean pressures are acceptable, and while her respiratory
acidemia is worsening. Increasing PEEP would also reduce her delivered minute
ventilation, because there would be a smaller pressure gradient between P[high]
and P[low]. Decreasing T[low] by 0.2 sec would probably have little effect. Her
oxygenation is fine; changing FiO2 is not necessary.
Question34 of 82 (score?)
A 64 year old man complains of shortness of breath after a successfulcoronary
artery bypass graft surgery 5 weeks prior. He is found to have a large left-sided
pleural effusion (about 50% of the hemithorax) and readmitted to his surgeon's
team. A thoracentesis drains 1,800 mL of fluid, relieving his dyspnea, A follow-up
chest film shows minimal remaining fluid. He had no other presenting symptoms
besides dyspnea, and is asymptomatic now. The fluid was exudative (LDH 400)
and had 1,100 white cells/mL, 71% lymphocytes. He looks and feels better and
wants to go home. The cardiothoracic surgeon asks you your opinion.
What's the best advice to give?](https://image.slidesharecdn.com/cases-150409121051-conversion-gate01/85/Real-World-Boards-Cases-PULMCCM-67-320.jpg)



































































![135
Tube thoracostomy, followed by instillation of tissue plasminogen activator and
DNAse was found to be superior to tube thoracostomywith either agent alone or
placebo in improving outcomes with PPE. Fewer patients who got combination t-
PA/DNAse needed surgery, and they went home sooner. Only 4% of patients in the
t-PA/DNAse group needed surgery within 3 months, suggesting this should usually
be an effective approach.
Since the internist did aspirate fluid, it's unlikely that the initial technique was
appropriate and that the low volume obtained was due to the loculations present;
repeat thoracentesis would be unlikely to help.
REFERENCES:
Colice GL et al. Medical and SurgicalTreatment of Parapneumonic
Effusions: an evidence based guideline. CHEST October 2000 vol. 118 no.4
1158-1171.
Lee SF et al. Thoracic empyema: current opinions in medical and surgical
management. Curr Opin Pulm Med. 2010 May;16(3):194-200. [PubMed]
Shi-Ping Luh et al. Video-Assisted Thoracoscopic Surgeryin the Treatment
of Complicated Parapneumonic Effusions or Empyemas: Outcomeof 234
Patients. CHESTApril 2005 vol. 127 no. 4 1427-1432.
Rahman NM et al. IntrapleuralUseof TissuePlasminogen Activator and
DNasein Pleural Infection. NEngl J Med 2011; 365:518-526.](https://image.slidesharecdn.com/cases-150409121051-conversion-gate01/85/Real-World-Boards-Cases-PULMCCM-135-320.jpg)
